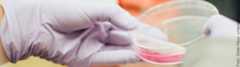
Foto eines Forschungsprozess.

Forschen
In Ihrem Forschungsprojekt unterstützen und beraten wir Sie im Bereich Datenmanagement. Forschende in Philosophie und Soziologie können sich über unsere Fachinformationsdienste vernetzen und ihre Ergebnisse sichtbar machen. Zusätzlich bieten wir Historiker*innen mit unserem großen Altbestand den direkten Einstieg in die Quellenforschung.